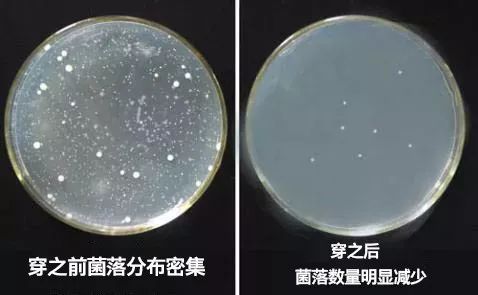
精致女生|比杜蕾斯还薄的*裤内**，舒适还很“安全”，穿上就像裸着一样

买对优选商城

新鲜+创意,精选最优质的商品!

作为一枚精致girl,
在挑*裤内**的时候,
你会先看哪一点?
性感?
舒适?
轻薄透气?
还是…安全?

相信姑娘们在挑*裤内**的时候,
美总是放在第一位的。

我觉得:
好看是必须的,
然而安全也万万不能忽视!
贴身穿的*裤内**
如果挑不好,
对*处私**的伤害可不是一点点!

作为一名成年女性,
相信很多女性朋友跟我一样,
也会时不时面临一些
难以启齿的妇科问题:
异味、瘙痒、白带异常……
即便每天洗澡换洗*裤内**
但是仍难以避免突然中招。

一般人都认为妇科问题肯定是由于:
个人卫生或是*生活性**不洁造成。
但是让你想不到的是,
诱导妇科病产生的原因,
80%竟然都跟*裤内**有关!


你会说:我每天都在洗*裤内**啊,
怎么就跟*裤内**有关系了?
是的,我们是每天都在换洗*裤内**
但是你发现没有,
无论怎么洗,*裤内**裆部还是
越来越黄,越来越硬。
其实根本原因就是
*处私**分泌物渗透进布料纤维里,
无法100%清洗干净,
越积越多之后导致裆部发黄变硬。

而这些沉积下来的分泌物恰恰是
细菌的最爱,
所以穿过一段时间的*裤内**裆部
简直就是
无数阴道细菌 的乐园。

而这样的*裤内**,
你每多穿一天,
就意味着多一次感染的机会!

所以想要杜绝妇科病
你要做的第一步就是选条安全的*裤内**
↓
今天推荐的这条
『Meryl Soft蜂窝抑菌*裤内**』
采用蜂窝纳米银裆部,抑菌率高达99%
堪称 “ *处私**细菌克星”
连妇科医生都推荐选择的抑菌*裤内**,
穿上它,细菌再也不能侵害你!
从源头杜绝细菌滋生,
远离*处私**瘙痒、异味,
时时刻刻都能做健康优雅的自己。

//
纳米银蜂窝抑菌裆部
有效抑制99%的细菌
//
一个好的裆部,是一条*裤内**的灵魂。
这条*裤内**的裆部厉害之处就在于
布料上面的蜂窝型结构设计,
添加的纳米银纤维材质,
能抑制99%的大肠杆菌等致病细菌。

纳米银纤维亲肤、柔软,
天然安全,
由于它强大的杀菌修复作用
一般用于医疗烫伤、烧伤包扎伤口。

关于纳米银强大的杀菌能力,
在医疗届早就开始广泛运用,
把银作为抗菌材料添加在裆部的布料里,
能强效杀菌,消除异味,
关键是它对妇科炎症还能起到很好的消炎作用。


尤其女生一到生理期,
身体免疫力下降,
病菌更容易侵入体内,
而裆部布料里的
蜂窝纳米银纤维强大的杀菌作用
能够将生理期滋生的细菌统统杀死,
彻底断绝妇科病的根源。

除了用纳米银加持裆部,
整条*裤内**使用的都是天然植物纤维,
安全绿色,对身体无害。
荧光剂测试数据为零,
杜绝一切致癌物!
//荧光剂测试//

//
冰丝面料轻薄透气、弹力吸湿
穿上就像没穿一样
//
一到夏天厚重不透气的*裤内**
会加重*处私**细菌的滋生,
而Meryl Soft采用的是冰丝面料,
冰丝纤维透气性、吸湿性
要比普通的纯棉纤维好6倍!

薄! 到!透!光!
夏天穿上它,
凉爽透气,
再也不用担心*处私**闷热瘙痒!

最怕遇上阴天和梅雨季,
*裤内**洗了干不了干着急…
Meryl Soft拥有超强吸湿速干的能力,
差不多上午洗了下午就能干!

冰丝既有纯棉吸湿透气的优点,
也有丝的亲肤丝滑,
提在手里冰凉、轻盈,
穿在身上好像会“呼吸”。

超轻超弹,穿上零存在感!
整条*裤内**的重量只有18g。

编辑小姐姐穿过之后说,
这轻薄丝滑的触感,
就像是给小PP敷了一层超贴身的面膜,
比杜蕾斯还轻薄,
穿上就像没穿一样!

即使在炎热的夏天,
也能让裆部能时刻保持清爽透气,
不会因为天气升温而觉得闷热!
*处私**时刻干燥透气,
病菌自然无处可藏。

360°完美包裹臀部,
分分钟穿出性感的蜜桃小翘臀。
别出心裁的花瓣形无痕剪边,
不勒大腿根凸显腿部修长柔美~
也更显女性的温柔可人。
穿上像是被轻柔的花瓣簇拥着,
真的是很仙啦!

//
一片式裁剪,一次成型
360°包裹就像是为你量身定做
//
夏天就是个穿仙女裙、包臀裙的日子,
这时候要是*裤内**太紧,卡了臀缝,
或是勒出臀印可就太尴尬了。

Meryl Soft*裤内**全部采用
进口氨纶胶无痕热压,
一片式裁剪,一次成型,
没有突起咯人的缝边,
穿在身上,完美贴合臀部,
就像是为你量身定做的一样舒适。
仙女们再也不担心尴尬的卡臀印了

超大弹力,
80-140斤的妹纸都可以穿
弹力宽腰设计,拉伸效果超级好,
穿在身上一点也不勒!
不管你是140斤的微胖仙女,
还是80斤的小仙女,
都可以轻松驾驭。
整条*裤内**弹力超大

无论是穿紧身裤还是包臀裙
都不透露半点痕迹!

//
天然植物纤维,超抗皱
怎么洗都不褪色、不变形
//
虽然冰丝跟纯棉都是天然植物纤维,
但冰丝比纯棉更抗皱,
就算多次水洗也不会变形,变硬。

莫代尔的支数是40S,冰丝支数60S,
支数越高越紧密,布料更不易变形。


天然环保的植物印染,
固色效果非常好,
用100℃沸水烫也不会掉色。

整条*裤内**摸起来就像细腻的肌肤,
穿在身上像羽毛一样轻柔,
丝滑的触感跟真丝有一拼,
但是价格还不到优质真丝的零头!
傲娇的品质,呆萌的价格
还等什么?
买它! 买它!
☟☟

每条*裤内**都是密封独立包装,
隔绝细菌,干净卫生。

-
还有黑色、 香槟色、 粉藕色、
-
淡蓝色,浅灰色,五色可选。

食物有保质期这个我们都知道,
但你知道吗?其实*裤内**也有保质期!
医生建议,每三个月换一次*裤内**。
备上一盒蜂窝抗菌*裤内**,
3条替换能穿3、4个月。
备两盒可以穿1年多!

选好*裤内**,保护*处私**,
比挑蓝朋友还重要!


【美爆了的仙女*裤内**】
花瓣形无痕剪边*裤内**
少女感满满!
粉丝专享价69元
长按识别二维码购买